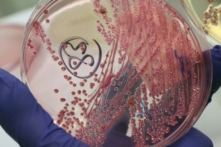
Bức ảnh tư liệu về hoạt động nuôi cấy vi khuẩn cho thấy tình trạng nhiễm trùng dương tính với vi khuẩn E. coli gây xuất huyết đường ruột, còn được gọi là vi khuẩn EHEC vào năm 2011. (Ảnh: Sean Gallup/Getty Images)

Cách tốt nhất để cung cấp nước mà không cần uống 8-12 ly nước mỗi ngày

Khi cung cấp đủ nước cho cơ thể thông qua thực phẩm hữu cơ, bạn sẽ có được tất cả các lợi ích.
Không nạp đủ nước thông qua thực phẩm có thể khiến bạn không bao giờ đạt được sức khỏe tối ưu (bao gồm cả việc đảo ngược tình trạng sức khỏe kinh niên)…
Chúng ta đã được kể một câu chuyện không đúng sự thật rằng để [cơ thể] có đủ nước, cần uống trung bình 8-12 ly nước mỗi ngày. Nhưng hiệu quả thực sự của việc này là như thế nào?
Trước tiên hãy xem xét chất lượng nước uống. Liệu nước đã được lọc chưa? Có chứa xenoestrogen gây rối loạn nội tiết tố không? Đựng trong chai thủy tinh hay thép không gỉ? Có được khoáng hóa tốt không?
Có rất nhiều mối nguy hiểm với nước. Cho dù là florua, clo, cặn nhựa hay một trong hàng chục những thứ khác đang làm ô nhiễm nguồn nước, thì việc có nguồn nước sạch, vốn vô cùng cần thiết cho một sức khỏe tốt, đang trở nên rất khó khăn.
Chỉ riêng lý do này đã khiến việc chỉ uống nước không có tác dụng cải thiện sức khỏe.
Nhưng nếu cung cấp nước cho cơ thể chủ yếu thông qua thực phẩm thì sao?
Mọi thứ đều sẽ thay đổi.
Khi cung cấp đủ nước thông qua thực phẩm hữu cơ, bạn sẽ có được tất cả các lợi ích.
Ví dụ như nhận được các vitamin, khoáng chất, enzyme và các dưỡng chất khác, vốn rất khó có hoặc không thể cung cấp từ nước. Suy dinh dưỡng hoặc mất cân bằng dinh dưỡng là một yếu tố chính gây ra bất kỳ bệnh tật nào. Và bạn không thể khắc phục điều đó [chỉ] thông qua việc uống nước.
Bạn cũng sẽ loại bỏ florua, clo, xenoestrogen và các hóa chất nhân tạo khác khi cung cấp nước cho cơ thể thông qua thực phẩm hữu cơ.
Ngoài ra, bạn cũng không nên tiêu thụ các sản phẩm “hút nước” trong cơ thể.
Vậy những thực phẩm nào là thủ phạm chính gây mất nước?
- Bột mì
- Sản phẩm động vật
- Cà phê
- Rượu
- Phô mai
Tất cả đều là những thứ mà phần lớn mọi người đều thường xuyên ăn/uống.
Nhưng điều này không có nghĩa là bạn không thể ăn bất kỳ một sản phẩm nào ở trên. Cần giảm thiểu tiêu thụ hết mức những thực phẩm này để cơ thể luôn được cung cấp nước thích hợp. Đây là yếu tố chính giúp loại bỏ bệnh tật và duy trì sức khỏe tốt.
Nói tóm lại, mất nước tạo ra và làm trầm trọng thêm nhiều vấn đề sức khỏe, và việc chỉ uống nước sẽ không phải là giải pháp khắc phục.
Cung cấp đủ nước qua thực phẩm không có nghĩa là bạn cần uống nước trái cây hàng ngày, mặc dù đó chắc chắn là một thói quen hữu ích. Hãy nên tập trung nhiều hơn vào các bữa ăn chính và đồ ăn nhẹ bổ sung nhiều nước hơn. Khi bạn học cách làm điều đó, bệnh tật sẽ bắt đầu biến mất và bạn có thể cảm thấy mình khỏe mạnh trở lại.
Thiên Vân biên dịch
Quý vị tham khảo bản gốc tại The Epoch Times